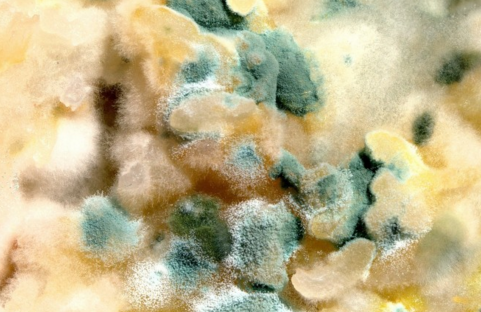

在农村养牲畜玉米是很常见的饲料,有时候因为天气原因会使玉米发潮发霉,自己辛苦种植的也不忍心丢弃,有的会用来继续喂养牲畜,那么,霉变饲料还能给牲畜吃吗?农民因喂养后损失十几头牛!(附治疗方案)
一、霉变饲料还能给牲畜吃吗?
不能用发霉、变质的残羹剩饭或饲料喂养家食家畜。这是因为发霉、变质的残羹剩饭或饲料中的有毒物质会大量积累在家禽家畜的体内,这不仅影响了家禽家畜的生长发育,而且人吃了这样的家禽家畜,也会因有毒物质进人人体而危害自已的身体健康。

二、农民因喂养后损失十几头牛!
由于存放不当有一袋玉米发生严重霉变,扔了感觉可惜,老王便将其掺合到饲料中喂牛。害怕喂了之后出问题开始掺合量比较小,每天仅喂一二十斤左右霉变玉米。前两天并无任何症状,老王便把剩余玉米全部掺合到了饲料里面。
问题来了第三天开始,部分牛出现食欲不振,反刍停止以及拉稀等症状。老王感觉问题不大,不再喂霉变玉米便没有事情了。可到第四天基本全群牛均出现类似症状,严重的甚至出现磨牙、转圈、后腿踢腹等症状。
老王感觉事情有些严重,找了多名兽医一致诊断为急性黄曲霉素中毒。

治疗方案
由于病牛较多,我们多名兽医一起联合进行治疗,不过任谁心里都没有底。在一起商量出了一个最佳治疗方案,便开始对病牛进行治疗。
1、清理胃肠内容物。停止饲喂任何草料,采用0.1%高锰酸钾溶液灌肠、洗胃,然后灌服硫酸镁进行缓泻。
养牛技术延伸:牛胃肠水较多时采用硫酸镁或硫酸钠进行缓泻效果较好,胃肠水少草料多时采用石蜡油等油类进行缓泻效果较好。
2、有磨牙、转圈等神经症状的牛,给与镇静止痉。
3、治疗时应注意强心补液、电解质平衡、保肝保肾与控制继发感染。10%安钠咖注射液30毫升,生理盐水1500毫升,5%葡萄糖注射液1500毫升,50%葡萄糖注射液500毫升,维生素C注射液50毫升,维生素K3注射液50毫升,三磷酸腺苷150毫克,肌苷1.5克,四环素800万单位,静脉进行注射,每日1次。同时口服制霉菌素3~5克。
经过两天两夜连续奋战,牛群整体情况稳定下来,不过最后仍然死掉八头牛,还有五六头牛需要淘汰。
霉变饲料一定不要喂牛!
无论草料还是精饲料,当出现肉眼可见的霉变时一定不要喂牛。当然不少养牛户心疼饲料浪费,像老王一样少量掺合着进行喂牛。这样做虽然不一定会出现急性霉菌中毒,但当霉菌毒素在牛体内累积到一定量时仍然会出现中毒。牛会出现采食量减少,生长缓慢,营养不良、被毛无光泽、逆立以及鼻镜干裂等症状。
大部分饲料虽然无肉眼可见霉变,但通过放大镜或显微镜仍可观察到一些霉斑。养牛户应在饲料中适当添加脱霉剂,尽可能降低霉菌毒素对牛健康以及生长带来的影响。





